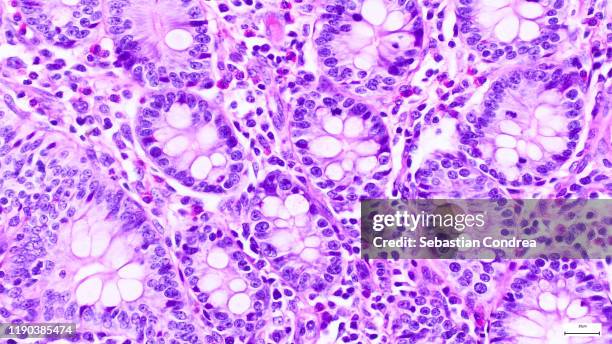
pancreas. serous acini, immunofluorescent photomicrograph, organs samples, histological examination, histopathology on the microscope. - tecido humano termo anatômico - fotografias e filmes do acervo

25.008 Tecido Humano Termo Anatômico Imagens e fotos de stock
Ver vídeos de tecido humano termo anatômico
Pesquise 25.008 fotos e imagens disponíveis de tecido humano termo anatômico ou inicie uma nova pesquisa para explorar mais fotos e imagens.

of100PRÓXIMA